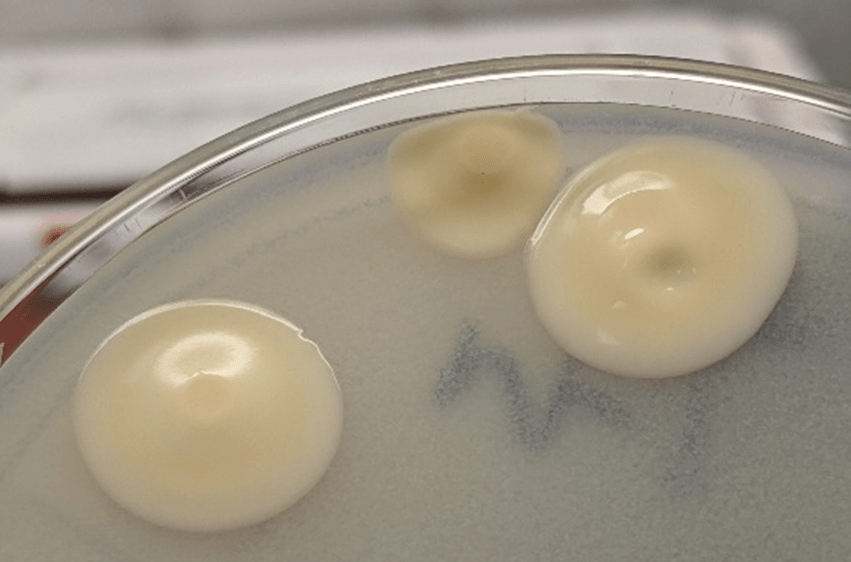

Clinical History
A 53 year old male with a past medical history significant for dermatomyositis, antisynthetase syndrome, and atrial fibrillation with rapid ventricular response presented with a chief complaint of worsening confusion, auditory hallucinations, and hearing loss. Pertinent medications included prednisone and mycophenolate. Head MRI demonstrated leptomeningeal enhancement and hydrocephalus. A lumbar puncture was performed, with CSF results as follows:

Laboratory Findings
CSF was sent to the microbiology lab for bacterial and fungal smears and cultures. No organisms were seen on the Gram stain.
Within 3 days, however, rare colonies of yeast were growing on both the bacterial and fungal media. The yeast was identified as Cryptococcus neoformans using the in-house MALDI-TOF mass spectrometry instrument.

Discussion
Cryptococcus neoformans is an environmental saprophytic yeast that can be found around the world, although it is often associated with avian droppings.1 The cell is surrounded by a polysaccharide capsule that protects it from environmental hazards and, once within the host, from phagocytosis.2 Additionally, the cell wall of C. neoformans contains melanin due to the presence of the phenol oxidase enzyme, which assists in the formation of melanin from various phenolic substrates.1 Both the polysaccharide capsule and the melanin-containing cell wall can be helpful in the laboratory identification of C. neoformans.
If inhaled, Cryptococcus neoformans can cause disease (cryptococcosis) in immunocompromised patients. The most significant risk factor is AIDS, however any cause of immunodeficiency can be a risk factor, including long-term steroid therapy, organ transplantation, malignancy, and liver disease.1 Once inhaled, the organism spreads hematogenously and tends to favor the central nervous system, causing cryptococcal meningoencephalitis.1
Prognosis for patients with cryptococcosis can vary widely. In AIDS-associated CNS cryptococcosis, predictors of mortality include abnormal mental status, cerebrospinal fluid antigen titer >1:1024 by latex agglutination or >1:4000 by lateral flow assay, and CSF white blood cell count <20/µL.1 The prognosis for patients who are immunocompromised for other reasons depends on the cause of their immunosuppression.1
Treatment of patients with cryptococcal meningoencephalitis consists of an induction phase with amphotericin B and flucytosine followed by a consolidation phase with fluconazole then a long-term maintenance phase with a smaller dose of fluconazole.3
References
- Jobson M. Microbiology and epidemiology of Cryptococcus neoformans infection. In: Post T, ed. UpToDate. UpToDate, Inc. Accessed March 13, 2021. https://www.uptodate.com
- Tille, Patricia M., PhD, BS, MT(ASCP) Facs. Bailey & Scott’s Diagnostic Microbiology. 14th ed. Elsevier; 2017.
- Perfect JR, Dismukes WE, Dromer F, et al. Clinical practice guidelines for the management of cryptococcal disease: 2010 update by the infectious diseases society of America. Clin Infect Dis. 2010;50(3):291-322. doi:10.1086/649858
-Michael Madrid, MD is a 1st year Anatomic and Clinical Pathology resident at the University of Vermont Medical Center.

-Christi Wojewoda, MD, is the Director of Clinical Microbiology at the University of Vermont Medical Center and an Associate Professor at the University of Vermont.